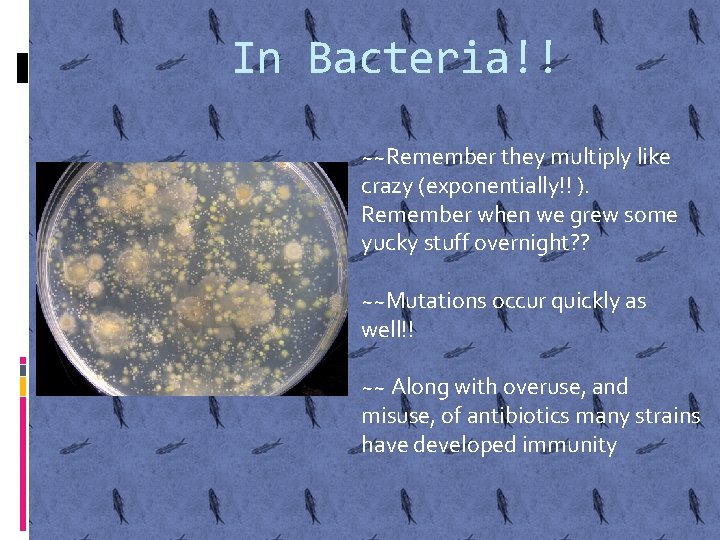
In Bacteria!! ~~Remember they multiply like crazy (exponentially!! ). Remember when we grew some

NATURAL SELECTION Natural Selection In a nutshell organisms

- Slides: 27
NATURAL SELECTION
Natural Selection………… In a nutshell, organisms with favorable phenotypes that allow for adaptation in a particular environment will survive, reproduce, pass their alleles along to their off spring Environment DOES NOT NECESSARILY MEAN THE WEATHER!!!! It simply indicates those that can withstand selective pressures such as: Selective pressures from competition for mates, for food, for shelter, escaping predators, acclimation to climate. Others may include physical features such as variation in beak size (must adapt to other food sources!)
Natural Selection First of all, it does NOT produce the perfect organism!! There are still fish that swim too slow and get eaten, not to mention the human genetic diseases out there!! However, there is genetic variation in populations of organisms (Remember genetic recombination in Meiosis? Mutations? Natural selection LEADS to evolution!
Example of Natural Selection
• In this fish population, individuals have variations. For example, they may differ in color, size, and speed.
• *Individuals with certain useful variations, (in this case speed) survive in their environment, passing those variations to the next generation.
* Over time, offspring with certain variations make up most of the population and may look entirely different from their ancestors.
Peppered Moth Video You Tube Title: Peppered Moth by Mark Drollinger http: //www. youtube. com/watch? v=s. VVldxxb Wig (2 minutes!!)
Fitness? ? **The word fitness describes how well a particular phenotype is at leaving offspring in the next generation relative to how good others. This does NOT mean the organism is the strongest…just the “best” suited **For example, if brown beetles consistently leave more offspring than green beetles because of their color (possibly less noticeable to predators) you’d say that the brown beetles had a higher fitness. Se say the brown phenotype is selected for. The brown beetles have a greater fitness relative to the green beetles.
Darwin’s Finches, Natural Selection and Fitness
Darwin and the Galapagos Finches Video You. Tube Title: Galapagos: the finches (4/7) http: //www. youtube. com/watch? v=l 25 MBq 8 T 77 w (2 minutes long!!)
What’s Up With The Finches? What do You Notice About Their Beaks? How Would You Explain This Observation?
A subspecies of this species is also known as the vampire finch as it will occasionally drink the blood of blue-footed booby nestlings
Natural selection not only affects finches, but insects, bacteria and viruses as well!!
In Bacteria!! ~~Remember they multiply like crazy (exponentially!! ). Remember when we grew some yucky stuff overnight? ? ~~Mutations occur quickly as well!! ~~ Along with overuse, and misuse, of antibiotics many strains have developed immunity
Antibiotics Are Medications Used to Kill, or at Least Slow Down, Bacterial Infections, Like Strep Throat
Antibiotic Resistance
Pesticide Resistance
Immunity Your Ability to Fight Off Infections and Diseases can be caused by bacteria, viruses, some protists and some fungi These are called pathogens Two basic types of acquired immunity Active Passive
Vaccines and Anti-Virals
Viruses Although viruses aren’t living, they have a single nucleic acid chain (either DNA or RNA) surrounded by a protein coat and capable of replication but only within the cells of living organisms
More About Viruses!! Virus that enter your body will attach themselves to a cell and insert its DNA, or RNA, into your cell that carries the instructions to make more viruses New viruses leave the cell to invade other cells However, your immune system can learn from these encounters and develop strategies to prevent reinfection. The next time the same virus comes to a host cell, it may find that it is no longer able to attach to the cell's surface membrane. So to survive, viruses must adapt or evolve, changing its surface proteins enough to trick the host cell into allowing it to attach.
Vaccines Help Guard Against
Antiviral Medications Antiviral resistance means that a virus has changed in such a way that the antiviral drug is less effective in treating or preventing illnesses caused by viruses, such as the flu The drug Tamiflu shortens the duration and severity of the flu Nucleic acids of the virus may change in a way that results in the virus becoming resistant to antiviral drugs
Mass Production of Tamiflu – The Antiviral Drug for Influenza